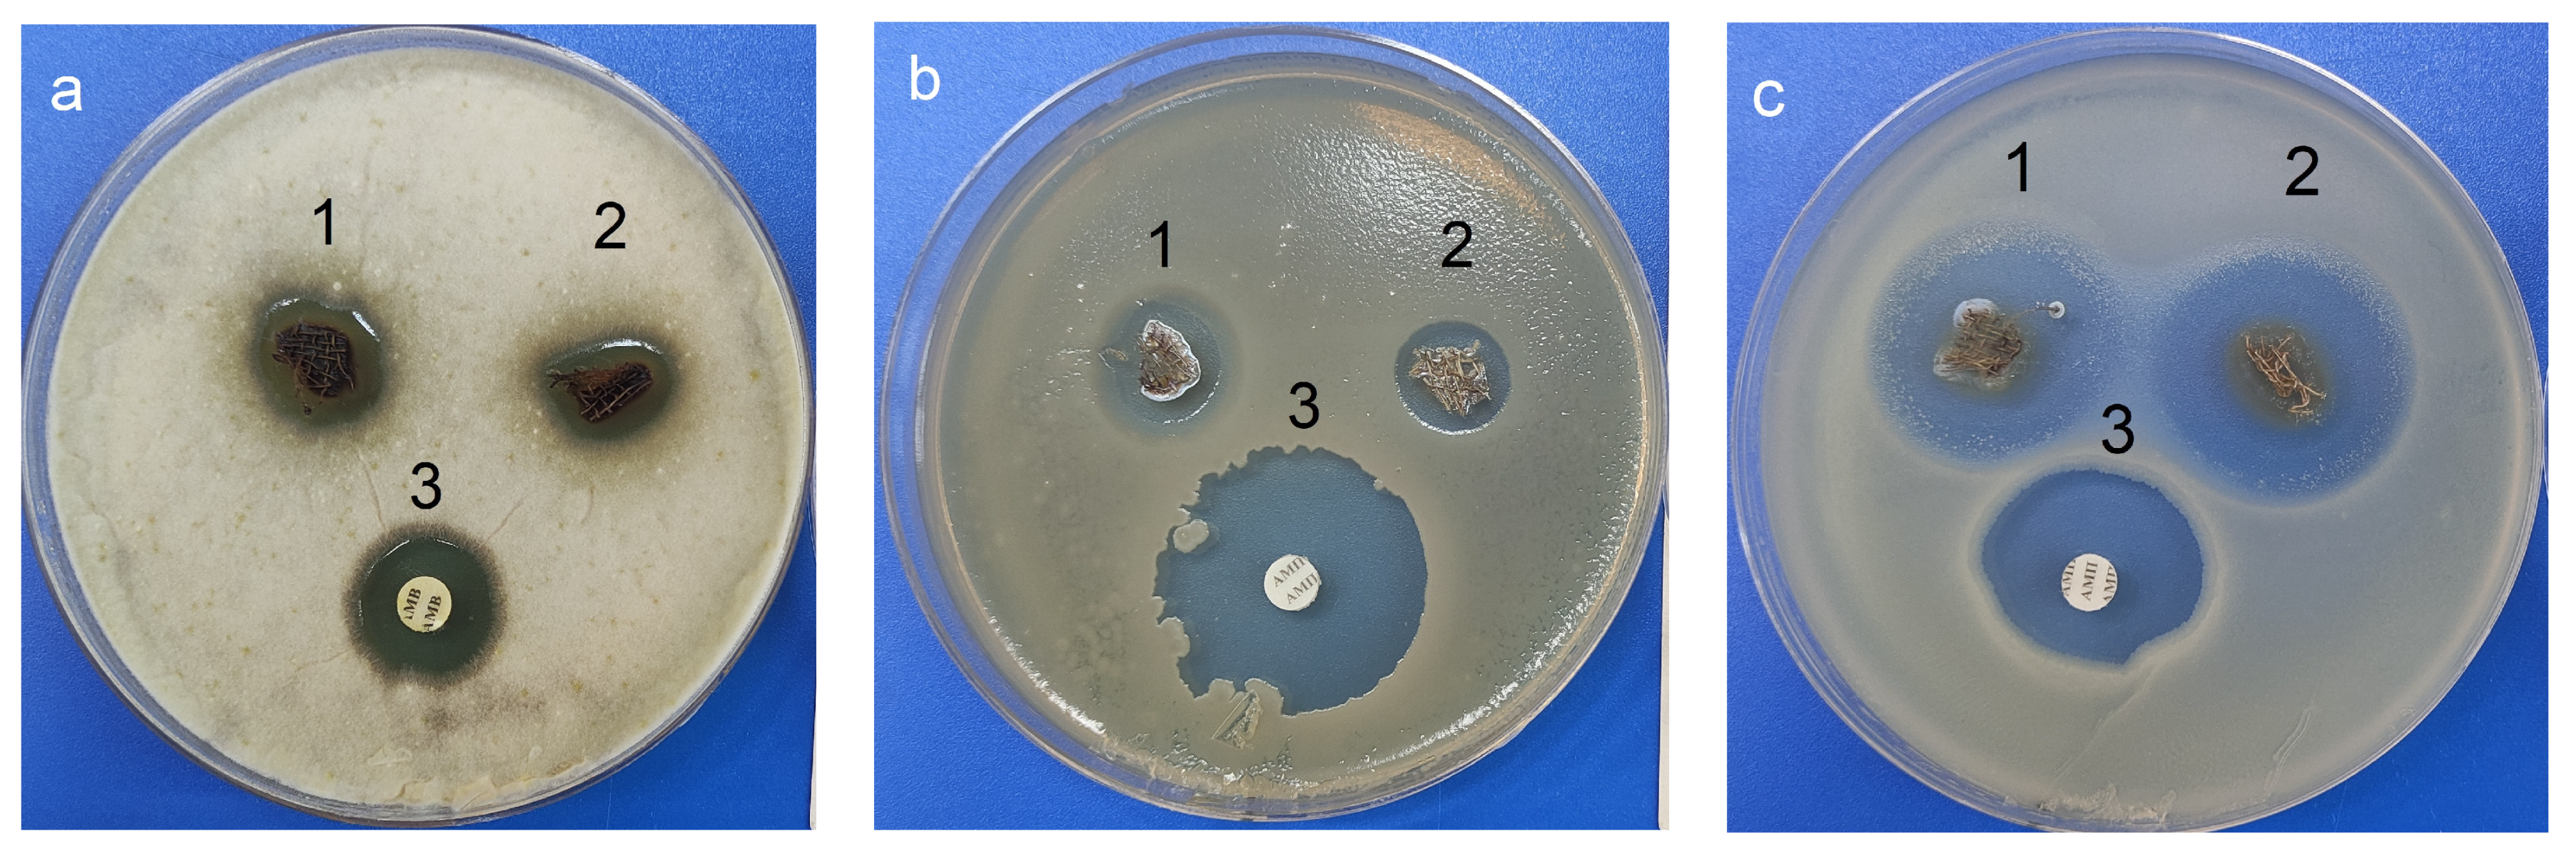
Pharmaceutics 15 00809 g015 Pharmaceutics 15 00809 g015

Hybrid Materials with Antimicrobial Properties Based on Hyperbranched Polyaminopropylalkoxysiloxanes Embedded with Ag Nanoparticles
Abstract
1. Introduction
2. Results and Discussion
3. Materials and Methods
3.1. Materials
3.1.1. Synthesis of Sodiumoxy-(3-aminopropyl)diethoxysilane (Figure 1)
3.1.2. Synthesis of Hyperbranched Poly(3-aminopropyl)ethoxysiloxane (Figure 2)
3.1.3. Synthesis of Nanocomposite Ag NPs/HBPAPES/Cotton
3.2. Methods
3.3. Estimation of DND Antimicrobial and Antifungal Activity
4. Conclusions
Supplementary Materials
Author Contributions
Funding
Institutional Review Board Statement
Informed Consent Statement
Data Availability Statement
Conflicts of Interest
References
- Fedotcheva, T.A.; Olenin, A.Y.; Starostin, K.M.; Lisichkin, G.V.; Banin, V.V.; Shimanovskii, N.L. Prospects for using gold, silver, and iron oxide nanoparticles for increasing the efficacy of chemotherapy. Pharm. Chem. J. 2015, 49, 220–230. [Google Scholar] [CrossRef]
- Gherasim, O.; Puiu, R.A.; Bîrca, A.C.; Burdus, A.-C.; Grumezescu, A.M. An Updated Review on Silver Nanoparticles in Biomedicine. Nanomaterials 2020, 10, 2318. [Google Scholar] [CrossRef]
- Bruna, T.; Maldonado-Bravo, F.; Jara, P.; Caro, N. Silver nanoparticles and their antibacterial applications. Int. J. Mol. Sci. 2021, 22, 7202. [Google Scholar] [CrossRef]
- Šupová, M.; Martynková, G.S.; Barabaszová, K. Effect of nanofillers dispersion in polymer matrices: A review. Sci. Adv. Mater. 2011, 3, 1–25. [Google Scholar] [CrossRef]
- Kang, H.; Buchman, J.; Rodriguez, R.; Ring, H.; He, J.; Bantz, K.; Haynes, C. Stabilization of silver and gold nanoparticles: Preservation and improvement of plasmonic functionalities. Chem. Rev. 2018, 119, 664–699. [Google Scholar] [CrossRef]
- Yang, L.; Yan, H.; Li, D.; Li, Y.; Zhao, Z. Study on the properties of silicon-modified polyurethane anticorrosion coating. Chem. Eng. Trans. 2017, 59, 103–108. [Google Scholar] [CrossRef]
- Li, Q.; Sun, L.; Zhang, L.; Xu, Z.; Kang, Y.; Xue, P. Polydopamine-collagen complex to enhance the biocompatibility of polydimethylsiloxane substrates for sustaining long-term culture of L929 fibroblasts and tendon stem cells. J. Biomed. Mater. Res. A 2018, 106, 408–418. [Google Scholar] [CrossRef]
- Razavi, M.; Primavera, R.; Vykunta, A.; Thakor, A.S. Silicone-based bioscaffolds for cellular therapies. Mater. Sci. Eng. C 2021, 119, 111615. [Google Scholar] [CrossRef]
- Pino, C.J.; Haselton, F.R.; Chang, M.S. Seeding of CornealWounds by Epithelial Cell Transfer from Micropatterned PDMS Contact Lenses. Cell Transplant. 2005, 14, 565–571. [Google Scholar] [CrossRef]
- Sanchez, C.; Belleville, P.; Popall, M.; Nicole, L. Applications of advanced hybrid organic–inorganic nanomaterials: From laboratory to market. Chem. Soc. Rev. 2011, 40, 696–753. [Google Scholar] [CrossRef]
- Demin, A.M.; Pershina, A.G.; Ivanov, V.V.; Nevskaya, K.V.; Shevelev, O.B.; Minin, A.S.; Byzov, I.V.; Sazonov, A.E.; Krasnov, V.P.; Ogorodova, L.M. 3-Aminopropylsilane-modiied iron oxide nanoparticles for contrast-enhanced magnetic resonance imaging of liver lesions induced by Opisthorchis felineus. Int. J. Nanomed. 2016, 11, 4451–4463. [Google Scholar] [CrossRef]
- Jeon, I.; Noh, H.; Baek, J. Hyperbranched macromolecules: From synthesis to applications. Molecules 2018, 23, 657. [Google Scholar] [CrossRef]
- Hu, X.; Zhou, L.; Gao, C. Hyperbranched polymers meet colloid nanocrystals: A promising avenue to multifunctional, robust nanohybrids. Colloid Polym. Sci. 2011, 289, 1299–1320. [Google Scholar] [CrossRef]
- Vasilkov, A.; Migulin, D.; Naumkin, A.; Belyakova, O.; Zubavichus, Y.; Abramchuk, S.; Maksimov, Y.; Novichikhin, S.; Muzafarov, A. Hybrid materials based on core-shell polyorganosilsesquioxanes modified with iron nanoparticles. Mend. Commun. 2016, 3, 187–190. [Google Scholar] [CrossRef]
- Vasil’kov, A.; Migulin, D.; Naumkin, A.; Zubavichus, Y.; Budnikov, A.; Ellert, O.; Maksimov, Y.; Muzafarov, A. Hybrid materials based on polymethylsilsesquioxanes containing Fe, Pt, and Fe–Pt metallic nanoparticles. Russ. J. Phys. Chem. 2017, 91, 2188–2194. [Google Scholar] [CrossRef]
- Migulin, D.; Milenin, S.; Cherkaev, G.; Svidchenko, E.; Surin, N.; Muzafarov, A. Sodiumoxy(aminopropyl)alkoxysilanes—AB2 type monomers for the synthesis of hyperbranched poly(aminopropyl)alkoxysiloxanes and their derivatives. J. Organomet. Chem. 2018, 859, 24–32. [Google Scholar] [CrossRef]
- Migulin, D.; Milenin, S.; Cherkaev, G.; Zezin, A.; Zezina, E.; Muzafarov, A. Sodium 3-azidopropyldialkoxysilanolate—A versatile route towards new functional 1,2,3–triazole based hyperbranched polyorganoalkoxysiloxanes. React. Funct. Polym. 2020, 154, 104648–104656. [Google Scholar] [CrossRef]
- Migulin, D.; Rozanova, J.; Migulin, V.; Cherkaev, G.; Meshkov, I.; Zezin, A.; Muzafarov, A. New types of hyperbranched 1,2,3-triazole-alkoxysiloxane functional polymers for metal embedded nanocomposite surface coatings. Soft Matter 2022, 18, 2441–2451. [Google Scholar] [CrossRef]
- Vasil’kov, A.; Migulin, D.; Muzalevskiy, V.; Naumkin, A.; Pereyaslavtsev, A.; Zubavichus, Y.; Nenajdenko, V.; Muzafarov, A. Copper-containing polymethylsilsesquioxane nanocomposites in catalytic olefination reaction. Mendeleev Commun. 2022, 32, 478–481. [Google Scholar] [CrossRef]
- Gao, C.; Yan, D. Hyperbranched polymers: From synthesis to applications. Prog. Polym. Sci. 2004, 29, 183–275. [Google Scholar] [CrossRef]
- Ibrahim, N.A.; Abd El-Ghany, N.A.; Eid, B.M.; Mabrouk, E.M. Green options for imparting antibacterial functionality to cotton fabrics. Int. J. Biol. Macromol. 2018, 111, 526–533. [Google Scholar] [CrossRef]
- Hanh, T.T.; Van Phu, D.; Thu, N.T.; Quoc le, A.; Duyen, D.N.B.; Hien, N.Q. Gamma irradiation of cotton fabrics in AgNO3 solution for preparation of antibacterial fabrics. Carbohydr. Polym. 2014, 101, 1243–1248. [Google Scholar] [CrossRef]
- Ribeiro, A.I.; Shvalya, V.; Cvelbar, U.; Silva, R.; Marques-Oliveira, R.; Remião, F.; Felgueiras, H.P.; Padrão, J.; Zille, A. Stabilization of Silver Nanoparticles on Polyester Fabric Using Organo-Matrices for Controlled Antimicrobial Performance. Polymers 2022, 14, 1138. [Google Scholar] [CrossRef]
- Boldyryeva, H.; Hlidek, P.; Biederman, H.; Slavinska, D.; Choukourov, A. Composite Ag/C:H films prepared by deposition. Thin Solid Films 2003, 442, 86–92. [Google Scholar] [CrossRef]
- Hlidek, P.; Hanus, J.; Biederman, H.; Slavinska, D.; Pesicka, J. Composite Ag/C:H:N films prepared by planar magnetron deposition. Thin Solid Films 2008, 516, 4581–4586. [Google Scholar] [CrossRef]
- Beier, O.; Pfuch, A.; Horn, K.; Weisser, J.; Schnabelrauch, M.; Schimanski, A. Low Temperature Deposition of Antibacterially Active Silicon Oxide Layers Containing Silver Nanoparticles, Prepared by Atmospheric Pressure Plasma Chemical Vapor Deposition. Plasma Process. Polym. 2013, 10, 77–87. [Google Scholar] [CrossRef]
- Ribeiro, A.I.; Modic, M.; Cvelbar, U.; Dinescu, G.; Mitu, B.; Nikiforov, A.; Leys, C.; Kuchakova, I.; Souto, A.P.; Zille, A. Atmospheric-Pressure Plasma Spray Deposition of Silver/HMDSO Nanocomposite on Polyamide 6,6 with Controllable Antibacterial Activity. AATCC J. Res. 2020, 7, 1–6. [Google Scholar] [CrossRef]
- Tseomashko, N.E.; Rai, M.; Vasil’kov, A.Y. New hybrid materials for wound cover dressings. In Bio-Polymer-Based Nano Films; Rai, M., Dos Santos, C.A., Eds.; Elsevier Inc.: Cambridge, MA, USA, 2021; pp. 203–245. [Google Scholar] [CrossRef]
- Vasil’kov, A.; Budnikov, A.; Gromovykh, T.; Pigaleva, M.; Sadykova, V.; Arkharova, N.; Naumkin, A. Effect of Bacterial Cellulose Plasma Treatment on the Biological Activity of Ag Nanoparticles Deposited Using Magnetron Deposition. Polymers 2022, 14, 3907. [Google Scholar] [CrossRef]
- Jose, D.; Jagirdar, B.R. Au@Pd core-shell nanoparticles through digestive ripening. J. Phys. Chem. C 2008, 112, 10089–10094. [Google Scholar] [CrossRef]
- Bhaskar, S.P.; Jagirdar, B.R. Digestive ripening: A synthetic method par excellence for core-shell, alloy, and composite nanostructured materials. J. Chem. Sci. 2012, 124, 1175–1180. [Google Scholar] [CrossRef]
- Balerna, A.; Evangelisti, C.; Psaro, R.; Fusini, G.; Carpita, A. Structural characterization of bimetallic Pd-Cu vapor derived catalysts. J. Phys.Conf. Ser. 2016, 712, 012057. [Google Scholar] [CrossRef]
- Vasil’kov, A.; Dovnar, R.; Smotryn, S.; Iaskevich, N.; Naumkin, A. Plasmon Resonance of Silver Nanoparticles as a Method of Increasing Their Antibacterial Action. Antibiotics 2018, 7, 80. [Google Scholar] [CrossRef]
- Rubina, M.S.; Said-Galiev, E.E.; Naumkin, A.V.; Shulenina, A.V.; Belyakova, O.A.; Vasil’kov, A.Y. Preparation and characterization of biomedical collagen–chitosan scaffolds with entrapped ibuprofen and silver nanoparticles. Polym. Eng. Sci. 2019, 59, 2479–2487. [Google Scholar] [CrossRef]
- Rubina, M.S.; Elmanovich, I.V.; Shulenina, A.V.; Peters, G.S.; Svetogorov, R.D.; Egorov, A.A.; Vasil’kov, A.Y. Chitosan aerogel containing silver nanoparticles: From metal-chitosan powder to porous material. Polym. Test. 2020, 86, 106481. [Google Scholar] [CrossRef]
- Vasil’kov, A.; Rubina, M.; Naumkin, A.; Buzin, M.; Dorovatovskii, P.; Peters, G.; Zubavichus, Y. Cellulose-Basedm Hydrogels and Aerogels Embedded with Silver Nanoparticles: Preparation and Characterization. Gels 2021, 7, 82. [Google Scholar] [CrossRef]
- Vasil’kov, A.; Rubina, M.; Naumkin, A.; Belyakova, O.; Zubavichus, Y.; Maksimov, Y.; Imshennik, V. Metal-containing systems based on chitosan and collagen-chitosan composite. Russ. Chem. Bull. 2015, 64, 1663–1670. [Google Scholar] [CrossRef]
- Rubina, M.S.; Kamitov, E.; Zubavichus, Y.; Peters, G.; Naumkin, A.; Suzer, S.; Vasil’kov, A. Collagen-chitosan scaffold modified with Au and Ag nanoparticles: Synthesis and structure. Appl. Surf. Sci. 2016, 366, 365–371. [Google Scholar] [CrossRef]
- Rubina, M.; Vasil’kov, A.; Naumkin, A.; Shtykova, E.; Abramchuk, S.; Alghuthaymi, M.; Abd-Elsalam, K. Synthesis and characterization of chitosan–copper nanocomposites and their fungicidal activity against two sclerotia-forming plant pathogenic fungi. J. Nanostruct. Chem. 2017, 7, 249–258. [Google Scholar] [CrossRef]
- Smetana, A.B.; Klabunde, K.J.; Marchin, G.R.; Sorensen, C.M. Biocidal activity of nanocrystalline silver powders and particles. Langmuir 2008, 24, 7457–7464. [Google Scholar] [CrossRef]
- Cárdenas, G.; Sáez, V.; Cruzat, C. Preparation of Gold Nanoparticles Using 2-Ethoxyethanol, 2-Methoxyethanol and 1,3-Butyleneglycol Supported in Chitosan. J. Clust. Sci. 2016, 28, 1127–1144. [Google Scholar] [CrossRef]
- Cardenas-Trivino, G.; Elgueta, C.; Vergara, L.; Ojeda, J.; Valenzuela, A.; Cruzat, C. Chitosan doped with nanoparticles of copper, nickel and cobalt. Int. J. Biol. Macromol. 2017, 104, 498–507. [Google Scholar] [CrossRef] [PubMed]
- Cárdenas, G.; Díaz, V.J.; Meléndrez, M.F.; Cruzat, C.C.; García Cancino, A. Colloidal Cu nanoparticles/chitosan composite film obtained by microwave heating for food package applications. Polym. Bull. 2009, 62, 511–524. [Google Scholar] [CrossRef]
- Harris, R.K.; Kimber, B.J. 29Si nuclear magnetic resonance studies of some oligo- and polymeric siloxanes. J. Organomet. Chem. 1974, 70, 43–49. [Google Scholar] [CrossRef]
- Suh, I.-K.; Ohta, H.; Waseda, Y. High-Temperature Thermal Expansion of Six Metallic Elements Measured by Dilatation Method and X-Ray Diffraction. J. Mater. Sci. 1988, 23, 757–760. [Google Scholar] [CrossRef]
- Patterson, A.L. The Scherrer Formula for X-ray Particle Size Determination. Phys. Rev. 1939, 56, 978–982. [Google Scholar] [CrossRef]
- Rumi, S.S.; Liyanage, S.; Abidi, N. Conversion of Low-Quality Cotton to Bioplastics. Cellulose 2021, 28, 2021–2038. [Google Scholar] [CrossRef]
- Prasad, B.L.V.; Stoeva, S.I.; Sorensen, C.M.; Zaikovski, V.; Klabunde, K.J. Gold Nanoparticles as Catalysts for Polymerization of Alkylsilanes to Siloxane Nanowires, Filaments, and Tubes. J. Am. Chem. Soc. 2003, 125, 10488–10489. [Google Scholar] [CrossRef]
- Prasad, B.L.V.; Stoeva, S.I.; Sorensen, C.M.; Klabunde, K.J.; Zaikovski, V. Novel method for the synthesis of siloxanenanowires and filaments using gold nanoparticle catalysts. Int. J. Nanosci. 2005, 4, 1007–1010. [Google Scholar] [CrossRef]
- Ertas, G.; Demirok, U.K.; Suzer, S. Enhanced peak separation in XPS with external biasing. Appl. Surf. Sci. 2005, 249, 12–15. [Google Scholar] [CrossRef]
- Yamashita, Y.; Yoshikawa, H.; Chikyow, T.; Kobayashi, K. Bias-voltage application in a hard x-ray photoelectron spectroscopic study of the interface states at oxide/Si (100) interfaces. J. Appl. Phys. 2013, 113, 163707. [Google Scholar] [CrossRef]
- Naumkin, A.V.; Vasil’kov, A.Y. Au-Ni and Au-Fe heterometallic systems: An X-ray photoelectron spectroscopy study. Russ. Chem. Bull. 2013, 62, 2559–2566. [Google Scholar] [CrossRef]
- Bergman, S.L.; Sahasrabudhe, G.S.; Ji, H.; Cava, R.J.; Bernasek, S.L. Useful X-ray photoelectron spectroscopy-based chemical tool: Differential charging studies of complex composite materials. Chem. Mater. 2017, 29, 4162–4166. [Google Scholar] [CrossRef]
- Bergman, S.L.; Ganguly, A.S.; Bernasek, S.L. XPS characterization of a plasmonic sensor for catalysis studies by controlled differential charging. J. Electron. Spectrosc. Relat. Phenom. 2018, 222, 88–94. [Google Scholar] [CrossRef]
- Beamson, G.; Briggs, D. High Resolution XPS of Organic Polymers: The Scienta ESCA300 Database; Wiley: Chichester, UK; New York, NY, USA, 1992; ISBN 978-0-471-93592-6. [Google Scholar]
- Hoflund, G.B.; Weaver, J.F.; Epling, W.S. AgO XPS spectra. Surf. Sci. Spectra 1994, 3, 163–168. [Google Scholar] [CrossRef]
- El-Naggar, M.E.; Hassabo, A.G.; Mohamed, A.L.; Shaheen, T.I. Surface modification of SiO2 coated ZnO nanoparticles for multifunctional cotton fabrics. J. Colloid Interface Sci. 2017, 498, 413–422. [Google Scholar] [CrossRef]
- Gao, Y.-N.; Wang, Y.; Yue, T.-N.; Weng, Y.-X.; Wang, M. Multifunctional Cotton Nonwoven Fabrics Coated with Silver Nanoparticles and Polymers for Antibacterial, Superhydrophobic and High Performance Microwave Shielding. J. Colloid Interface Sci. 2021, 582, 112–123. [Google Scholar] [CrossRef]

| Sample | Zone of Inhibition, mm | |||
|---|---|---|---|---|
| B. subtilis ATCC 6633 | S. aureus ATCC 25923 | E. coli ATCC 25922 | A. niger INA 00760 | |
| Ag NPs/HBPAPES/cotton | 15 ± 0.4 | 7 ± 1 | 26 ± 1 | 13 ± 1 |
| Ag NPs/HBPAPES/cotton-2 (re-impregnated sample) | 15 ± 1 | 8 ± 0.1 | 30 ± 1 | 13 ± 0.7 |
| Amoxiclav 10 µg | 29 ± 0.3 | 25 ± 0.3 | 25 ± 0.1 | * nt |
| Amphotericin B 40 µg | * nt | * nt | * nt | 15 ± 0.6 |
Disclaimer/Publisher’s Note: The statements, opinions and data contained in all publications are solely those of the individual author(s) and contributor(s) and not of MDPI and/or the editor(s). MDPI and/or the editor(s) disclaim responsibility for any injury to people or property resulting from any ideas, methods, instructions or products referred to in the content. |
© 2023 by the authors. Licensee MDPI, Basel, Switzerland. This article is an open access article distributed under the terms and conditions of the Creative Commons Attribution (CC BY) license (https://creativecommons.org/licenses/by/4.0/).
Share and Cite
Vasil’kov, A.; Migulin, D.; Naumkin, A.; Volkov, I.; Butenko, I.; Golub, A.; Sadykova, V.; Muzafarov, A. Hybrid Materials with Antimicrobial Properties Based on Hyperbranched Polyaminopropylalkoxysiloxanes Embedded with Ag Nanoparticles. Pharmaceutics 2023, 15, 809. https://doi.org/10.3390/pharmaceutics15030809
Vasil’kov A, Migulin D, Naumkin A, Volkov I, Butenko I, Golub A, Sadykova V, Muzafarov A. Hybrid Materials with Antimicrobial Properties Based on Hyperbranched Polyaminopropylalkoxysiloxanes Embedded with Ag Nanoparticles. Pharmaceutics. 2023; 15(3):809. https://doi.org/10.3390/pharmaceutics15030809
Chicago/Turabian StyleVasil’kov, Alexander, Dmitry Migulin, Alexander Naumkin, Ilya Volkov, Ivan Butenko, Alexandre Golub, Vera Sadykova, and Aziz Muzafarov. 2023. "Hybrid Materials with Antimicrobial Properties Based on Hyperbranched Polyaminopropylalkoxysiloxanes Embedded with Ag Nanoparticles" Pharmaceutics 15, no. 3: 809. https://doi.org/10.3390/pharmaceutics15030809
APA StyleVasil’kov, A., Migulin, D., Naumkin, A., Volkov, I., Butenko, I., Golub, A., Sadykova, V., & Muzafarov, A. (2023). Hybrid Materials with Antimicrobial Properties Based on Hyperbranched Polyaminopropylalkoxysiloxanes Embedded with Ag Nanoparticles. Pharmaceutics, 15(3), 809. https://doi.org/10.3390/pharmaceutics15030809

